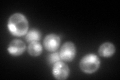
YNL007C
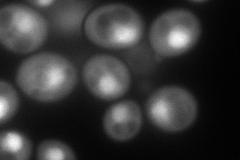
YNL007C

View description
Type II HSP40 co-chaperone that interacts with the HSP70 protein Ssa1p; not functionally redundant with Ydj1p due to due to substrate specificity; shares similarity with bacterial DnaJ proteins
Localization:
Intensity:
Fold change:
Significance:
-
C’ GFP library in SD
nucleus, cytosol241.92 -
N' NOP1pr-GFP in SD
cytosol,nucleus192.678 -
N' TEF2pr-mCherry in SD

cytosol,nucleus180.102 -
N' NATIVEpr-GFP in SD

nucleus329.093 -
N' TEF2pr-VC and Cyto-VN in SD

nucleus44.1343 -
C’ GFP library in SD+DTT

punctate332.411.37No -
C’ GFP library in SD+H2O2

nucleus, cytosol324.431.34No -
C’ GFP library in Starvation Media

nucleus, cytosol446.551.84Yes -
C’ GFP library on the background of Pup2-DaMP

nucleus, cytosol -
C’ GFP library on the background of CCT mutant

nucleus, cytosol312.5881.29209No
